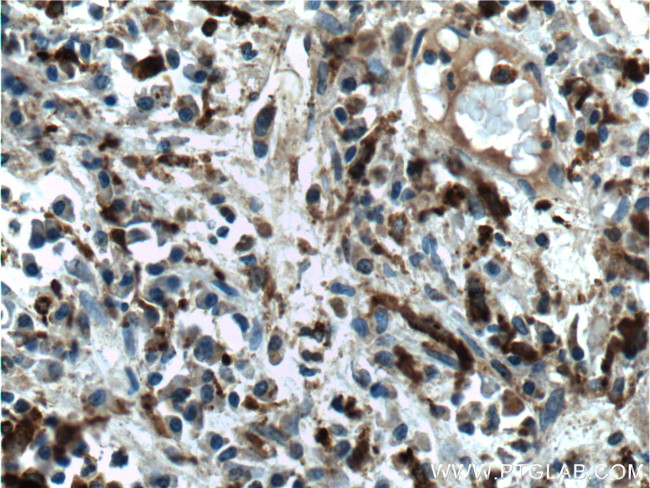
PSAP Antibody in Immunohistochemistry (Paraffin) (IHC (P))

Search
Proteintech
PSAP Monoclonal Antibody (2F11B2)
{{$productOrderCtrl.translations['antibody.pdp.commerceCard.promotion.promotions']}}
{{$productOrderCtrl.translations['antibody.pdp.commerceCard.promotion.viewpromo']}}
{{$productOrderCtrl.translations['antibody.pdp.commerceCard.promotion.promocode']}}: {{promo.promoCode}} {{promo.promoTitle}} {{promo.promoDescription}}. {{$productOrderCtrl.translations['antibody.pdp.commerceCard.promotion.learnmore']}}
产品信息
66473-1-IG
种属反应
宿主/亚型
分类
类型
克隆号
抗原
偶联物
形式
浓度
规格
纯化类型
保存液
内含物
保存条件
运输条件
产品详细信息
Immunogen sequence: MYALFLLAS LLGAALAGPV LGLKECTRGS AVWCQNVKTA SDCGAVKHCL QTVWNKPTVK SLPCDICKDV VTAAGDMLKD NATEEEILVY LEKTCDWLPK PNMSASCKEI VDSYLPVILD IIKGEMSRPG EVCSALNLCE SLQKHLAELN HQKQLESNKI PELDMTEVVA PFMANIPLLL YPQDGPRSKP QPKDNGDVCQ DCIQMVTDIQ TAVRTNSTFV QALVEHVKEE CDRLGPGMAD ICKNYISQYS EIAIQMMMHM QPKEICALVG FCDEVKEMPM QTLVPAKVAS KNVIPALELV EPIKKHEVPA KSDVYCEVCE F (1-320 aa encoded by BC001503)
靶标信息
PSAP is a highly conserved glycoprotein which is a precursor for 4 cleavage products: saposins A, B, C, and D. Each domain of the precursor protein is approximately 80 amino acid residues long with nearly identical placement of cysteine residues and glycosylation sites. Saposins A-D localize primarily to the lysosomal compartment where they facilitate the catabolism of glycosphingolipids with short oligosaccharide groups. The precursor protein exists both as a secretory protein and as an integral membrane protein and has neurotrophic activities.
仅用于科研。不用于诊断过程。未经明确授权不得转售。
篇参考文献 (0)
生物信息学
蛋白别名: co-beta glucosidase precursor; precursor of saposins; Proactivator polypeptide; Prosaposin; PSAP; saposin-A; saposin-B; saposin-C; saposin-D; sphingolipid activator protein-1; sphingolipid activator protein-2; unnamed protein product
基因别名: GLBA; PARK24; PSAP; PSAPD; SAP1; SAP2
UniProt ID: (Human) P07602
Entrez Gene ID: (Human) 5660